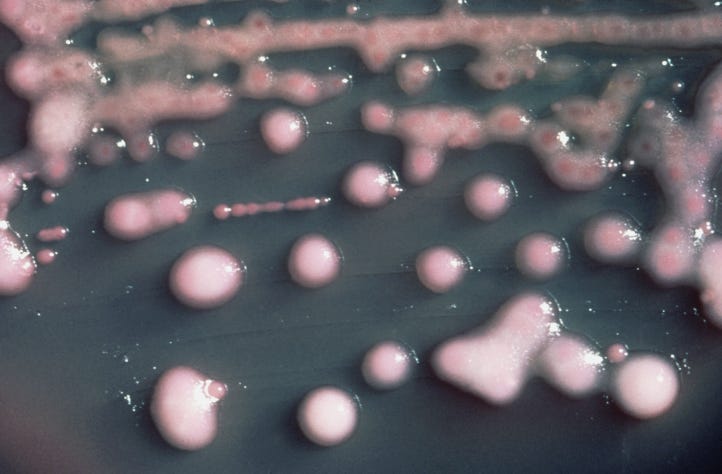

Можем ли мы прокачать свой микробиом?
Как микробы внутри нас влияют на организм и что в популярных разговорах о микробиоме правда, а что миф.
Представьте себе абсолютного идейного трезвенника. Он утверждает, что не пьёт даже кефир, – но постоянно ощущает себя в состоянии сильнейшего алкогольного опьянения. Алкоголь находят у него в крови и в воздухе, который он выдыхает. Поэтому он не может водить машину. Когда он ходит, его шатает. Он потерял несколько работ. У него серьезные проблемы со здоровьем. И при этом многие ему не верят. Ну нельзя же быть вечно пьяным, если тайком не наворачиваешь стопочку коньяка или портвейна.
Но наш герой и правда не употребляет алкоголь. Алкоголь сам производится у него внутри. И подобных случаев в науке зафиксированы десятки. Называется это синдромом автопивоварни. Недавно про него вышло свежее исследование в журнале Nature Microbiology. А вызывается синдром микроорганизмами, живущими в кишечнике. Это страшное, хоть и очень редкое заболевание – лишь один из множества примеров того, как сильно мы зависим от нашего микробиома.
Микробиом — это совокупность всех микроорганизмов, обитающих в определенной среде, например, в теле человека или в конкретном органе, плюс весь их генетический материал. Мы с вами покрыты микроорганизмами с головы до ног, снаружи и внутри. Они живут в кишечнике, во рту, в носу, в легких и даже на поверхности глаз. Какие-то безвредные, какие-то производят витамины и питательные вещества для клеток кишечника, какие-то вредят.
Внутри каждого из нас живет не просто набор микробов, а целая микробная цивилизация. Причем не одна, а сразу несколько. С разными культурами, экономикой, внутренними конфликтами, альянсами и правилами выживания. Наш микробиом — это одновременно и экосистема, и социум. Там есть плотные “города”, а есть приграничные территории. Есть постоянные жители, а есть туристы, заглянувшие ненадолго.
И с этой точки зрения отношения между нами и микробиомом очень похожи на отношения между человеком и окружающей средой. Для микробов мы — их мир. Их климат, почва, реки и атмосфера. Мы меняем этот мир едой, лекарствами, образом жизни. Мы можем сделать его комфортней для одних микробов и сущим адом для других. Но и микробы могут по-разному относиться к своей среде обитания. Иногда они живут в гармонии с нами, не вредят или даже помогают. Иногда они начинают нас эксплуатировать, что порой ведет к смерти экосистемы. То есть нас. И вместе с нами погибает микробная цивилизация.
Как изучают микробиом
Когда пытаются изучать цивилизацию, то обычно начинают с описания населения. Возможно, вы слышали, что бактериальных клеток в человеке в 10 раз больше, чем собственных клеток организма. Это, конечно, ложь. И все же, по современным оценкам, на каждую клетку человека приходится хотя бы одна клетка какого-нибудь микроорганизма, будь то бактерия, гриб или архея, живущая на нас или внутри нас. По размерам эти клетки сильно меньше наших родных, так что по массе микробиом нам все же уступает.
Ну а что там с разнообразием микробиома? Только в кишечнике у человека обнаружено несколько тысяч видов бактерий.
Во рту обитает около 700 видов. В свое время я участвовал в исследованиях микробиома человеческого глаза. Там тоже огромное разнообразие, которое, кстати, резко меняется при глазных инфекциях. И даже, например, при ношении линз.
Раньше, когда ученый хотел исследовать микроба, обитающего в кишечнике или на поверхности глаза, ему обязательно нужно было его выделить, культивировать и вырастить. Подобрать ему благоприятную питательную среду, температуру, субстрат. Причем многие микробы капризничали и не хотели расти в лабораторных условиях, как бы ученые их не уговаривали. Для многих микробов подходящих условий культивации мы так и не подобрали.
Но тут пришла она метагеномика – раздел молекулярной биологии, который изучает совокупность генетического материала всех организмов в образце. Причем без необходимости выделять и выращивать отдельные виды микробов.
История метагеномики начинается отнюдь не с изучения кишечника. В 1998 году группа американских ученых проанализировала образцы ДНК из почвы. Далее ученые ввели термин метагеном: смесь геномов, то есть ДНК, тысяч «некультивируемых» микроорганизмов, живущих в образце. Из этой метагеномной ДНК они выделяли гены неизвестных микробов и засовывали их в обычных культивируемых бактерий типа кишечной палочки. Оказалось, что так можно обнаружить и выделить гены, отвечающие за производство какого-нибудь антибиотика. Таким образом почва становится базой данных ранее неизвестных программ биосинтеза. А мы получаем возможность изучать генетику микроорганизмов, которых вообще никто никогда в глаза не видел.
В 2004 году у метагеномики случился очередной прорыв. Ученые прочитали метагеном Саргассового моря.
Черпаем воду, выделяем ДНК и анализируем подряд любую обнаруженную в ней ДНК. Ищем гены новых, скрытых от глаз видов. Изучаем их. Тут снова получается генетический анализ целой экосистемы.
Но в этой работе про Саргассово море ученые совсем пошли в разнос. Если авторы исследования про почву искали какие-то конкретные гены, пусть и неизвестных организмов, и куда-то их встраивали для изучения, то тут авторы пошли по методу мясорубки. Или, вернее, дробовика. Да, он так и называется. Берем воду, отфильтровываем микроорганизмы, выделяем всю ДНК, режем ее на маленькие фрагменты, устанавливаем последовательности нуклеотидов этих случайных фрагментов методами чтения ДНК и загружаем все это в компьютер. А потом цифровыми методами склеиваем похожие, перекрывающиеся фрагменты ДНК вместе. И узнаем последовательности более длинных фрагментов ДНК.
В итоге авторы показали, что мы сильно недооцениваем многообразие жизни в природе. Они нашли тысячи новых генов, новые метаболические пути и создали современную метагеномику. Теперь ни одному микробу было не скрыться.
И вот исследователи побежали изучать многообразие микробов человека. Глазами микробиома наши ладошки, подмышки, кишечник, рот - богатые экосистемы. Одни виды микроорганизмов живут с нами постоянно, другие временно. Причем состав микробиома меняется от поведения и привычек, диеты, взаимодействий с другими людьми и возраста. Поцеловались? Обменялись микробиомом.
В 2007 году был запущен проект “Микробиом человека”.
Его цель состояла в детальном анализе многообразия микробов, которые живут на разных частях нашего тела, и анализе связей между составом микробиома и различными заболеваниями. Ну и дальше пошло-поехало. Сам анализ микробиома со временем стал дешевле и проще. Например, можно анализировать не всю ДНК, а только некоторые наиболее распространенные гены, которые хорошо выдают видовую принадлежность микроба.
Кстати, благодаря метагеномике ученым удалось раскрыть ту самую тайную микролабораторию по производству этанола внутри человека. В исследовании ученые наблюдали за 22 пациентами с синдромом автопивоварни и сравнивали их с сожителями, не имеющими данного заболевания. С помощью метагеномики ученые смогли определить состав бактерий и набор их метаболических генов. Оказалось, что у пациентов с синдромом автопивоварни резко увеличено количество некоторых бактерий, например, Klebsiella pneumoniae, некоторые штаммы которых обладают нехилыми способностями к ферментированию углеводов.
А если их число разрастется… вечная пьянка!
Впрочем, без сложностей в метагеномике не обойтись: забор материала не всегда устроен просто, а образцы должны быть свежими. Очень серьезно стоит проблема загрязнений. Кроме того, методы анализа ДНК часто разнятся между лабораториями и не всегда сопоставимы. И все же за последние десятилетия мы узнали об удивительных микробных сожителях очень много интересного. Например, что бактерии могут общаться.
Бактерии общаются
Общение между бактериями – чувство кворума – подробно изучено. Возможно, в школе вы читали про азотфиксирующие бактерии, которые живут в клубеньках у бобовых растений. И вот у них тоже обнаружен механизм кворума. Он позволяет им поддерживать оптимальную плотность популяции для максимально эффективной фиксации азота.
Чувство кворума играет огромную роль у некоторых бактерий, вызывающих серьезные инфекции у людей. Так, синегнойная палочка Pseudomonas aeruginosa вызывает опасные инфекции в больничных условиях. Бактерии этого вида используют чувство кворума для координации формирования плотных биопленок, которые защищают их от внешней среды, иммунной системы и антибиотиков.
Поиск и разработка веществ для блокировки коммуникации бактерий активно ведется. Есть такое вещество – фуранон. В малой концентрации у него приятный запах клубники, поэтому его используют в парфюмерии. А в природе его можно найти, например, в ананасе и томатах. Так вот, есть исследования, показывающие, что фуранон мешает коммуникации синегнойных палочек. Эти бактерии препятствуют заживлению ран, образуя на тканях биопленки. Считается, что до 60% хронических ран ассоциированы с бактериальными биопленками. И авторы одного исследования показали, что фуранон снижал образование биопленок синегнойной палочкой на 98,8%!
Подавление чувства кворума называют кворум-квенчинг. И, что интересно, на такое способны и некоторые бактерии. Одни бактерии могут мешать общаться другим. Например, есть бактерия Listeria, которую мы можем подхватить из загрязненной пищи. Обычно болезнь проходит просто с диареей, тошнотой, лихорадкой и головной болью. Но для людей с ослабленным иммунитетом она смертельно опасна. Так вот, у Listeria чувство кворума тоже влияет на формирование биопленок, а еще на производство молекул, повреждающих ткани организма человека. Но есть супергерой – бактерия Lactobacillus acidophilus.
Она используется для производства ацидофилина – это что-то вроде кефира. И эта бактерия умеет производить белки, которые, по предварительным данным, мешают злобным Listeria достигать чувства кворума. То есть, возможно, одна из функций здорового микробиома – подавлять коммуникацию враждебных бактерий, чтобы те не слишком высовывались.
Бактерии общаются с нами
Бактерии, живущие в нашем кишечнике, вырабатывают огромное количество всевозможных веществ и метаболитов. Бактерии могут даже химически влиять на чувство насыщения – то есть на набор веса и аппетит. Как это происходит? Некоторые бактерии производят короткоцепочную жирную кислоту пропионат, которая регулирует выделение ряда кишечных гормонов, в том числе знаменитого GLP-1, гормона насыщения. Именно его аналогом является действующее вещество Оземпика.
А как вам такой забавный факт? Более 90% серотонина в организме человека синтезируется отнюдь не в мозге, а в кишечнике. В эпителии нашего кишечника сидят особые клетки, выполняющие роль «химических сенсоров» и производящие различные гормоны и нейромедиаторы. А бактерии умеют на них воздействовать своими метаболитами, в том числе короткоцепочными жирными кислотами. В кишечнике серотонин влияет прежде всего на перистальтику, а значит, на продвижение содержимого, ну и на чувствительные нейроны, передающие сигналы из кишечника в мозг.
В науке есть даже концепция – ось микробиом-кишечник-мозг.
Этой осью, кстати, пытаются объяснить, почему некоторые антидепрессанты снижают неприятные ощущения в кишечнике. Но могут ли микробы влиять на депрессию? Возможно, что да. В 2016 году вышло занятное исследование. Авторы взяли 34 пациентов с депрессией и 33 – из контрольной группы. Из группы с депрессией выбрали самых депрессивных, а из контроля — самых счастливых. И пересадили их кишечную микробиоту крысам.
Перед этим крыс обрабатывали антибиотиками, чтобы максимально убрать их родной микробиом. У крыс, которые получили микробиоту от людей с депрессией, была более выражена ангедония, то есть меньшая склонность к получению удовольствия. Они меньше пили воду с сахаром, а еще проводили меньше времени в центре открытого поля, что является признаком тревожности. К слову, недавно вышел метаанализ, в котором показали, что трансплантация фекальной микробиоты и правда может облегчать симптомы депрессии, особенно у пациентов с синдром раздраженного кишечника.
Микробы ожирения
В 2006 году в журнале Nature вышло исследование, в котором учёные сравнили состав микробиома толстых и худых мышей из одного помета, а также толстых и худых людей. Авторы обнаружили, что “жирный” микробиом обладает большей способностью к извлечению энергии из пищи, а различия в ожирении лучше всего предсказываются относительным изобилием двух обширных групп бактерий. Но дальше – самое интересное. Ученые взяли мышей, которых пролечили антибиотиками. И пересаживали им микробиоту либо от толстых, либо от худых сородичей. “Толстая” микробиота приводила к более выраженному набору веса. То есть микробы могут делать нас толстыми!
В журнале Science есть еще более аккуратная работа. Там ученые разыскали девушек-близняшек. Гены одинаковые, но одна худая, другая полная. И тоже пересадили их микробиоту мышам. И результат оказался похожим.
Если мышей, которым пересадили “жирную” микробиоту, поселить вместе с мышами, получившими “худую” микробиоту, то развитие ожирения подавлялось. То есть передача микробов, влияющих на набор веса, может осуществляться без сложных процедур, а просто путем сожительства. По крайней мере, у мышей. Захотел похудеть – найди худого партнера или партнершу и поживи с ним! Причем речь не только про лишний вес, но и про некоторые расстройства метаболизма. Кстати, есть исследования, что люди, живущие под одной крышей, и правда имеют более похожие микробиомы. Особенно это заметно у партнеров. Самое сильное сходство видно в микробиоме кожи, но оно наблюдается и в микробиоме рта и кишечника.
Микробиом и болезни
Рецидивирующая инфекция Clostridium difficile, часто возникающая после приема антибиотиков, плохо ими лечится. Бактерия к ним устойчива. Это одна из самых опасных антибиотик-ассоциированных инфекций, особенно для пожилых людей и пациентов с ослабленным иммунитетом.
Инфекция проявляется многократной водянистой диареей, болью в животе, температурой и слабостью. В некоторых случаях может случиться перфорация кишечника, сепсис – и наступить смерть. Одобренным FDA решением стала пересадка фекальной микробиоты от здорового человека. Либо прямо в толстую кишку, либо с помощью оральной капсулы. При таком лечении часто нормальная микробиота вытесняет патогенную – и человек выздоравливает.
Полезен ли микробиом
Есть мнение, что обычные живущие в нас микробы полезны и являются нашими симбионтами. Другие считают, что мы бы прекрасно справились и без бактерий, а польза от них если и есть, то в том, что менее вредные бактерии вытесняют более вредные.
Я уже привел некоторые аргументы в пользу первой гипотезы, обозначив ряд полезных веществ, которые может синтезировать кишечный микробиом. Но и в пользу второй гипотезы тоже есть аргументы. Например, грызуны, выращенные с рождения в стерильных условиях, чувствуют себя не хуже грызунов со здоровым микробиомом. Более того, по данным некоторых исследований, они даже живут чуточку дольше – в среднем 89 недель против 76 в контрольной группе. То есть мыши могли спокойно жить без развитого кишечного микробиома, а значит, микробы не являются жизненно необходимыми спутниками нашей жизни.
А еще микробиом не лучшим образом связан с нашим старением. С возрастом у организма усиливается так называемое системное воспаление. Это воспаление часто называют стерильным, подчеркивая, что оно возникает не из-за явных инфекций, а из-за внутренних сбоев в работе клеток. Так было принято считать. Но вот авторы недавнего исследования, опубликованного в журнале Cell, обнаружили, что у мышей, от рождения живших в стерильных условиях, с возрастом не наблюдается повышения уровней целого ряда провоспалительных сигналов. А еще больший процент таких мышей доживали до мышиной старости.
Если таких мышей из стерильных условий подселять к старым обычным мышам с обычной микробиотой, то признаки воспаления появлялись. Чего не происходило при подселении к молодым обычным мышам. Авторы заключили, что к старости может формироваться неблагоприятная кишечная микробиота, усиливающая воспаление. Даже здоровая микробиота без всяких патогенов в какой-то момент может сработать против нас. Тогда, может, стоит бороться со старением, омолаживая микробиом кишечника?
Известно, что с возрастом снижается разнообразие кишечного микробиома – и это снижение будто бы коррелирует с рядом старческих заболеваний. В журнале Nature Aging есть статья, авторы которой пересадили старым мышам микробиоту молодых – и увидели частичное улучшение работы иммунной системы, когнитивных функций и других косвенных признаков старения по сравнению с пересадкой микробиоты от старых мышей. Впрочем, как это сказалось на продолжительности жизни, авторы умалчивают.
Прокачать микробиом
Одним из самых известных скептиков касательно пользы кишечных бактерий был Илья Мечников. Мечников считал, что в толстой кишке происходят процессы гниения, образуются токсичные метаболиты, которые вредят организму. И выход из этой ситуации он видел, например, в регулярном приеме кисломолочных продуктов. Такой и была логика: вытеснять более вредные микробы менее вредными.
Сейчас мы знаем, что микробиом сложно назвать вредным или полезным. Тем более, что у разных людей он разный. Но попытки его как-то улучшить и сделать более полезным кажутся осмысленными.
Действительно, некоторые эпидемиологические исследования выявили пользу для продолжительности жизни от ферментированного молока, но очень небольшую. Вот в чем проблема. Бифидобактерии обычно доминируют в кишечнике новорожденных. Но с возрастом уживаются в нас все хуже и хуже. В детском кишечнике, куда постоянно поступает молоко – и мало чего кроме молока, бифидобактерии чувствуют себя хорошо, но условия жизни с возрастом меняются. Меняется диета, а еще созревает иммунная система, появляется все больше бактерий-конкурентов. Мы можем залить в себя бифидобактерий – и какой-то временный эффект, может, даже и будет, но они просто продолжат проигрывать войну за существование в нашем кишечнике.
У пробиотиков есть медицинские показания, но они довольно ограничены. Да, бактерии из пробиотиков действительно попадают в кишечник, это проверяли. Да, они могут какое-то время в нем существовать. Но обычно они плохо выдерживают конкуренцию с типичным для данного конкретного человека микробиомом.
Например, в одном исследовании изучали пробиотики широкого спектра, в составе которых было 11 разновидностей бактерий. Их давали мышам в течение месяца и сравнивали с плацебо. Если мыши от рождения жили в стерильных условиях, то в этом случае пробиотики могли колонизировать кишечник. Но если у мышей уже была своя микробиота, как у нас с вами, то они вызывали лишь временные и небольшие изменения в составе кишечного микробиома.
Причем оказалось, что даже временные изменения не всегда полезны. Да, у пробиотиков есть и темная сторона. Иногда они делают только хуже.
Например, было слепое рандомизированное исследование, опубликованное в The Lancet. Оно проводилось на пациентах с острым панкреатитом – болезнью поджелудочной железы. Одной группе давали плацебо, другой — пробиотик, который содержал большое количество разных видов условно полезных бактерий. В группе пробиотиков умерло 16% пациентов, а в группе плацебо — только 6%. Исследователям показалось, что они убивают пациентов, поэтому эксперимент прекратили досрочно. И таких провальных исследований было несколько.
Все, что может иметь эффект, может иметь и побочный эффект. Любое медицинское вмешательство должно быть изученным в рамках доказательной медицины и оправданным с учетом рисков.
И все же я смог найти очень специфические ситуации, где пробиотики помогали. Во-первых, пробиотики часто назначают для того, чтобы предотвратить диарею на фоне приема антибиотиков. В одной из работ на фоне приема антибиотиков в контрольной группе диарея возникала у 19% пациентов, а в группе пробиотиков — у 8%.
Еще пробиотики имеют некоторое применение при диарее, вызванной конкретной Clostridium difficile. Той самой, при которой делают пересадку кала. В одном обзоре исследований пробиотик снижал риск повторной инфекции аж на 60%. К перспективным, но еще плохо изученным, можно отнести особый пробиотик VSL#3, который исследуется при язвенном колите. В одном эксперименте он снижал риск кишечных кровотечений. Но в целом, как видите, применение пробиотиков крайне ограничено.
Микробиом и еда
Некоторые кишечные бактерии умеют подстраиваться под нашу диету. Например, бактерия Bacteroides thetaiotaomicron активно меняет работу своих генов в зависимости от того, что мы едим.
Если в рационе появляется новый сахар, бактерия активирует гены для его расщепления. Ну а если человек переходит на диету с низким содержанием клетчатки, бактерия начинает вырабатывать ферменты для поедания защитной слизи вашего собственного кишечника.
На микробиом кишечника очень сильно влияет количество клетчатки. Клетчатка – это растительные волокна. Клетчатка является пребиотиком — веществом, которое служит “едой” для бактерий. Когда полезные бактерии поедают пребиотики, они выделяют различные метаболиты. Например, бутират. А это – основной источник питания для колоноцитов, то есть эпителиальных клеток толстой кишки. Недостаток бутирата может приводить к атрофии и повышенной проницаемости слизистой.
Существуют бактерии, которым для выживания и сохранения в кишечнике клетчатка крайне необходима. И бактерии, любящие клетчатку, относительно полезные – если сравнивать с конкурентами. Те же бифидобактерии ее любят. А у патогенных бактерий, как правило, нет нужных ферментов, чтобы расщепить эти сложные волокна. Может, отчасти поэтому потребление клетчатки ассоциировано с меньшей смертностью от всех причин.
Клетчатку можно получать из разных продуктов растительного происхождения. Ее даже можно купить отдельно, в виде добавки. Хотя лучше есть больше фруктов и овощей.
Что еще может влиять на микробиом? Например, соотношение белков, жиров и углеводов в пище. Едите ли вы ферментированные продукты, насколько разнообразно питаетесь и так далее. К сожалению, в большинстве случаев непонятно, как это влияние описать и оценить.
Увы, на фоне этой неопределенности полно мифов и спекуляций. Например, людям предлагают персонализированные диеты на основе анализа микробиома. Но тут нет хорошей доказательной базы. По большому счету, о пользе тех или иных диет мы знаем из эпидемиологических исследований на больших выборках, которые никакой микробиом не учитывали. И в целом любому человеку можно рекомендовать примерно одно и то же. Ешьте больше фруктов, овощей, меньше процессированного мяса, не переедайте. Средиземноморская диета хороша.
Мифы о кишечнике
Вы наверняка слышали о синдроме “дырявого кишечника”. На него часто списывают чуть ли не все болезни подряд. Да, бывают состояния, при которых нарушается барьерная функция кишечника. Может повреждаться слизистая, может повышаться проницаемость кишечной стенки. Но в медицинской практике диагноз “дырявый кишечник” не используется. Когда мы слышим этот термин – это такой красный флаг. Обычно дальше нам пытаются продать какие-то БАДы, курсы или схемы лечения кишечника.
Если кишечник становится более проницаемым, то это следствие конкретного заболевания или инфекции. И лечить нужно конкретную причину — то есть основную болезнь, а не абстрактный “дырявый кишечник”. Ну и, конечно, если вы слышите такие слова как детокс, чистка, хакинг микробиома – это все ерунда и обычный маркетинг. Никакой научной базы под этим нет.
Еще один популярный миф – что якобы по микробиому можно описать личность человека. Такая микросоционика. На самом деле микробиом максимум может кое-что сказать о ваших диетических предпочтениях и, может быть, о месте проживания. Разнообразная микробиота не делает человека более общительным, хотя, возможно, если быть слишком общительным, можно свою микробиоту ненароком разнообразить. Главное – не чем-то патогенным.
И напоследок
Даже если бактерий в нас не больше, чем наших собственных клеток, все равно очевидно, что они играют колоссальную роль, которую мы пока еще не до конца понимаем. Благодаря современным методам этого понимания становится чуточку больше.
В этом посте мы подробно разобрали кишечник. Но это только одна из таких микробных цивилизаций. У нас их несколько, и каждая живет по своим правилам.
Например, возьмем рот. В микробиоме рта есть бактерия, которая практически в одиночку отвечает за развитие кариеса. Называется она Streptococcus mutans.
Эта бактерия отлично себя чувствует во влажной среде рта, особенно когда у нее есть доступ к сахарам. Она активно перерабатывает их и производит молочную кислоту. А молочная кислота разрушает зубную эмаль. Не потому, что бактерия “злая”, а потому, что так устроена ее природа, ее цивилизация.
Другой пример — вагинальный микробиом. В здоровом состоянии там, как правило, доминируют лактобактерии. Это, по сути, отдельная цивилизация, которая поддерживает кислую среду и тем самым подавляет рост многих патогенных микроорганизмов. Бывают варианты нормы, при которых вагинальный микробиом остается здоровым и без жесткого доминирования лактобактерий, но в среднем именно они задают структуру этой экосистемы. В разных частях тела условно здоровая цивилизация — разная. То, что хорошо для влагалища, не имеет никакого смысла для кишечника. То, что критично для младенца, не нужно взрослому.
Есть еще один пример, который мне особенно близок – микробиом глаза. Там тоже есть свое сообщество микроорганизмов. Если человек начинает носить контактные линзы, это меняет условия среды. Появляется инородная поверхность, меняется влажность, доступ кислорода, механическое воздействие. И глазной микробиом на это реагирует. Его состав меняется. Не обязательно в плохую сторону, но экосистема подстраивается под новые условия.
То есть мы видим одну и ту же картину снова и снова. Меняются условия — меняется цивилизация. Мы добавили линзу — изменился микробиом глаза. Мы изменили диету — изменился микробиом кишечника. Мы применили антибиотик — пережили микробный апокалипсис с последующим восстановлением. Желательно без диктатуры патогенных клостридий.
Эти цивилизации на нас и внутри нас одновременно очень устойчивы и очень изменчивы. Совсем как мир и цивилизация, в котором мы с вами живем. Какие-то вещи мы не в силах пока изменить, а на что-то все же можем повлиять.
Подписывайтесь на соц. сети:
Бусти / Патреон / Instagram / Telegram / Youtube / TikTok
Мой авторский цикл лекций
Моя настолка
Источники